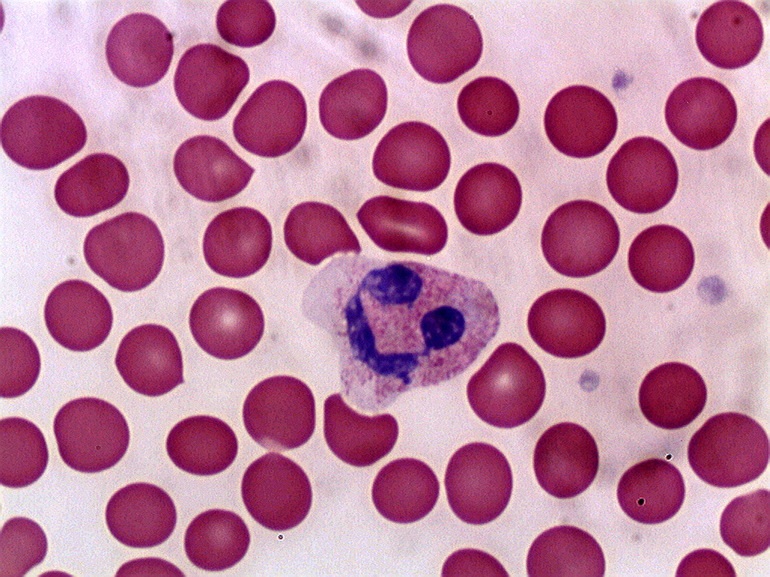
Макроцитоз эритроцитов

Анизоцитоз — состояние, при котором изменяется размер клеток крови. Это может указывать на различные заболевания и нарушения в организме. В статье рассмотрим виды анизоцитоза, причины его возникновения, методы диагностики и лечения. Понимание анизоцитоза и его роли в общем анализе крови поможет читателям лучше интерпретировать свои анализы, выявлять отклонения и принимать меры для поддержания здоровья.
Общая информация
Нормальный человеческий эритроцит представляет собой двояковогнутую безъядерную клетку круглой формы, размер которой колеблется от 6,8 до 7,7 мкм. Красные кровяные тельца стандартного размера составляют около 70% от общего объема крови, в то время как измененные эритроциты не должны превышать 30%.
В редких случаях может наблюдаться анизоцитоз тромбоцитов. Эти клетки имеют круглую форму, не содержат ядра и напоминают кровяные пластинки, их размер не превышает 3 мкм. Допустимые пределы отклонения для таких клеток находятся в диапазоне 14—17%. Превышение этих значений может свидетельствовать о прогрессировании определенного заболевания у пациента.
https://youtube.com/watch?v=PzxtYCY6y6o
Анизоцитоз является важным показателем в общем анализе крови, который привлекает внимание врачей при диагностике различных заболеваний. Специалисты отмечают, что наличие эритроцитов разного размера может свидетельствовать о нарушениях в организме, таких как анемия, дефицит витаминов или хронические заболевания. Врачи подчеркивают, что анизоцитоз не является самостоятельным диагнозом, а лишь симптомом, требующим дальнейшего исследования. При выявлении этого показателя важно учитывать клиническую картину и другие лабораторные данные. Врачи рекомендуют пациентам не игнорировать результаты анализа и обращаться за консультацией, чтобы своевременно выявить и устранить возможные причины анизоцитоза.
Причины отклонений
Анизоцитоз, выявляемый в общем анализе крови, указывает на наличие различных заболеваний. К числу наиболее распространенных анемий относятся:
- сидеробластная анемия;
- железодефицитная анемия;
- гиповитаминоз А;
- В12-фолиеводефицитная анемия;
- гемотрансфузия;
- значительная потеря крови;
- онкологические заболевания;
- патологии костного мозга, приводящие к изменениям полипотентных стволовых клеток;
- заболевания печени;
- гипотиреоз;
- беременность;
- острые формы интоксикации.
| Показатель | Описание | Клиническое значение |
|---|---|---|
| Анизоцитоз | Различие в размерах эритроцитов, превышающее норму. | Указывает на нарушение эритропоэза (процесса образования эритроцитов). |
| RDW (ширина распределения эритроцитов по объему) | Количественный показатель анизоцитоза. | Повышение RDW свидетельствует о наличии эритроцитов разных размеров. |
| Нормоциты | Эритроциты нормального размера (7-8 мкм). | Основная масса эритроцитов в норме. |
| Микроциты | Эритроциты уменьшенного размера (< 6 мкм). | Характерны для железодефицитной анемии, талассемии. |
| Макроциты | Эритроциты увеличенного размера (> 9 мкм). | Характерны для В12-дефицитной и фолиеводефицитной анемии, заболеваний печени. |
| Смешанный анизоцитоз | Присутствие как микроцитов, так и макроцитов. | Может наблюдаться при некоторых видах анемий, миелодиспластических синдромах. |
| Степень анизоцитоза | Оценивается по количеству эритроцитов с измененным размером. | Легкая, умеренная, выраженная. |
| Причины анизоцитоза | Анемии (различные виды), миелодиспластические синдромы, заболевания печени, почек, хронические воспалительные процессы. | Требует дальнейшей диагностики для выявления основной причины. |
Распространенные виды
Анизоцитоз эритроцитов классифицируется в зависимости от размеров кровяных клеток. Существует несколько типов данной патологии:
- макроцитоз, при котором диаметр клеток превышает 7,8 мкм;
- микроцитоз, характеризующийся размерами клеток менее 6,7 мкм;
- анизоцитоз смешанного типа, свидетельствующий о наличии эритроцитов с различными диаметрами;
- мегалоцитоз — клетки размером от 12 мкм и более.
В зависимости от процентного соотношения измененных клеток к общему количеству эритроцитов, анизоцитоз делится на несколько категорий, отражающих стадии его прогрессирования. Выделяют следующие типы анизоцитоза:
- Низкий, незначительный — обозначается в лаборатории знаком «+”. Процент мега-, макро- и микроцитов составляет до 25% от общего числа эритроцитов.
- Умеренное отклонение фиксируется знаком «++”, что указывает на содержание измененных клеток до 50%.
- Явный показатель — «+++”, обозначает, что патологические клетки составляют 50% и более.
- Высокий уровень, при котором почти все стандартные эритроциты заменены увеличенными или уменьшенными аналогами — «++++”.
Отдельно специалисты выделяют шизоцитоз, который определяется как наличие обломков эритроцитов в периферической крови, размером от 2 до 3 мкм. Реже встречается микросфероцитоз, который характеризуется наличием красных шаровидных клеток размером от 4 до 6 мкм.
https://youtube.com/watch?v=wcRC-2Qxgcs
Определение признаков
Основная задача эритроцитов заключается в транспортировке газов. В связи с этим анизоцитоз может привести к кислородному голоданию в тканях и органах, что проявляется следующими симптомами:
- выраженная одышка;
- нарастающая слабость;
- снижение концентрации внимания;
- уменьшение работоспособности;
- учащенное сердцебиение;
- трудности с выполнением привычных физических нагрузок;
- частые головные боли и головокружения;
- бледность слизистых оболочек и кожи;
- непредсказуемые колебания между бессонницей и сонливостью.
Данное состояние является ярким индикатором патологических процессов, происходящих в организме. Анизоцитоз сам по себе не является отдельным заболеванием, а проявляется в сочетании с симптомами основного недуга.

Протекание у беременных и детей
У новорожденных физиологически выраженный макроцитоз наблюдается в течение первых 2-3 недель жизни. Обычно нормализация кровяной формулы происходит самостоятельно в течение следующих двух месяцев. Если в детском возрасте были перенесены какие-либо инфекции, может быть диагностирован умеренный реактивный анизоцитоз.
Что касается женщин в период беременности и тех, кто кормит грудью, у них часто наблюдается прогрессирование микроанизоцитоза умеренной степени или мегалоцитоза, что свидетельствует о развитии анемии.
Диагностические меры
Основным критерием для диагностики анизоцитоза является выявление в анализируемом материале (крови) клеток с аномальными размерами. В редких случаях может проводиться дополнительное исследование с использованием гистограммы Прайс-Джонса, где эритроциты сортируются по их диаметру.
У здорового человека кривая эритроцитометрии имеет правильную треугольную форму с узким основанием и высокой вершиной. В большинстве случаев преобладают эритроциты размером 6—8 мкм, которые составляют примерно 75% от общего объема. В ситуации, когда наблюдается анизоцитоз, количество макроцитов и микроцитов становится примерно равным, составляя около 12—15%.
Форма кривой указывает на степень анизоцитоза, а положение максимума отражает средний размер эритроцитов. Если в ходе лабораторного анализа линия Прайс-Джонса смещена влево, это свидетельствует о наличии микроцитоза, тогда как смещение вправо с увеличением основания указывает на макроцитоз.
https://youtube.com/watch?v=FOFmqMh1NoE
Принципы лечения
Данный диагноз не является независимым, а служит индикатором существующей патологии в организме. В связи с этим, отдельное лечение не назначается. Если в анализе крови пациента выявляется высокий процент клеток с аномальными размерами, необходимо обратиться к специалисту, который определит, какое заболевание требует терапии.
Кроме лабораторных анализов, часто применяются и инструментальные методы исследования. После выяснения причин анизоцитоза и установления точного диагноза пациентупредписывается целенаправленное лечение:
- дезинтоксикационные мероприятия;
- прием железосодержащих и витаминных препаратов в случае анемии;
- использование тиреоидных медикаментов;
- проведение лучевой и химиотерапии при наличии злокачественных новообразований.
Профилактические процедуры
Анизоцитоз не представляет собой отдельное заболевание, а лишь сигнализирует о наличии патологий, которые требуют внимания и лечения. Важно следовать рекомендациям врача и применять простые профилактические меры, чтобы избежать ухудшения состояния здоровья.
Для предотвращения анемии и нормализации уровня гемоглобина рекомендуется включать в рацион определенные продукты и регулярно проходить анализы крови. Недостаток железа, который может угрожать жизни, можно компенсировать сбалансированным питанием. В рацион должны входить мясо, разнообразные овощи и орехи, бобовые, гранаты и печень. Такой подход поможет в профилактике анемии и анизоцитоза.
При хорошем самочувствии и отсутствии хронических заболеваний или воспалительных процессов, влияющих на органы или системы, размеры кровяных клеток остаются в пределах нормы. Однако, если организм страдает от заболевания, анизоцитоз исчезнет после соответствующего лечения.
Занятия спортом также являются отличным решением. Регулярные пробежки и тренировки в зале способствуют ускорению обмена веществ, улучшению кровообращения и насыщению тканей кислородом на клеточном уровне. Физическая активность помогает предотвратить развитие многих серьезных заболеваний, а отказ от вредных привычек укрепляет иммунную систему.
Анизоцитоз является показателем патологических изменений в организме. Избавиться от этого состояния возможно только путем устранения основной причины и повышения уровня гемоглобина. С улучшением здоровья размеры кровяных клеток приходят в норму.

Связь с другими заболеваниями
Анизоцитоз, характеризующийся изменением размера эритроцитов в крови, может быть связан с различными заболеваниями и состояниями организма. Понимание этой связи имеет важное значение для диагностики и лечения. Анизоцитоз часто наблюдается при анемиях, где изменение размеров красных кровяных клеток может указывать на тип и степень заболевания.
Одним из наиболее распространенных заболеваний, связанных с анизоцитозом, является железодефицитная анемия. В этом случае наблюдается увеличение количества микроцитов (маленьких эритроцитов) и макроцитов (больших эритроцитов), что свидетельствует о недостатке железа в организме. Это состояние может возникать из-за недостаточного потребления железа с пищей, потерь крови или нарушений всасывания.
Другим заболеванием, при котором часто наблюдается анизоцитоз, является мегалобластная анемия, вызванная дефицитом витамина B12 или фолиевой кислоты. В этом случае увеличивается количество макроцитов, что связано с нарушением процесса созревания эритроцитов в костном мозге. Дефицит этих витаминов может быть вызван неправильным питанием, заболеваниями желудочно-кишечного тракта или нарушениями всасывания.
Кроме того, анизоцитоз может быть признаком хронических заболеваний, таких как хронические инфекции, воспалительные процессы или опухолевые заболевания. В таких случаях изменение размеров эритроцитов может быть связано с реакцией организма на воспаление или с нарушением кроветворения в костном мозге.
Важно отметить, что анизоцитоз не является самостоятельным заболеванием, а служит лишь маркером, указывающим на наличие других патологий. Поэтому для точной диагностики необходимо проводить комплексное обследование, включая дополнительные анализы и исследования. Это позволит выявить основное заболевание и назначить соответствующее лечение.
В заключение, анизоцитоз в общем анализе крови может быть связан с множеством заболеваний, и его выявление требует внимательного анализа клинической картины и дополнительных исследований. Правильная интерпретация результатов анализа крови поможет врачу установить диагноз и выбрать оптимальную стратегию лечения для пациента.
Клинические проявления
Анизоцитоз, характеризующийся изменением размера эритроцитов в крови, может проявляться различными клиническими симптомами, в зависимости от причины его возникновения и степени выраженности. Важно отметить, что анизоцитоз сам по себе не является заболеванием, а скорее признаком, указывающим на наличие определенных патологий.
Одним из наиболее распространенных клинических проявлений анизоцитоза является анемия, которая может сопровождаться такими симптомами, как:
- Усталость и слабость: Пациенты могут ощущать постоянную усталость, даже после достаточного отдыха, что связано с недостаточным количеством кислорода, доставляемого к тканям.
- Головокружение и обмороки: Изменение размеров эритроцитов может влиять на их способность переносить кислород, что может приводить к головокружению, особенно при резком изменении положения тела.
- Бледность кожи и слизистых оболочек: При снижении уровня гемоглобина, что часто сопровождает анизоцитоз, кожа может приобретать бледный оттенок.
- Учащенное сердцебиение: Сердце может работать быстрее, пытаясь компенсировать недостаток кислорода в организме.
Кроме того, анизоцитоз может быть связан с различными заболеваниями, такими как:
- Недостаток витаминов: Дефицит витаминов группы B, особенно B12 и фолиевой кислоты, может приводить к изменению размеров эритроцитов и, как следствие, к анизоцитозу.
- Хронические заболевания: Заболевания, такие как хроническая почечная недостаточность или воспалительные процессы, могут влиять на образование и созревание эритроцитов, вызывая их анизоцитоз.
- Злокачественные новообразования: Некоторые виды рака, особенно те, которые затрагивают костный мозг, могут приводить к аномалиям в формировании кровяных клеток, включая анизоцитоз.
Важно отметить, что анизоцитоз может быть как временным, так и постоянным состоянием. Временный анизоцитоз может возникать в результате острых состояний, таких как инфекционные болезни или острые кровопотери, тогда как постоянный анизоцитоз чаще всего указывает на хронические заболевания.
Для диагностики анизоцитоза и определения его причин необходимо провести комплексное обследование, включая общий анализ крови, биохимические тесты и, при необходимости, дополнительные исследования. Лечение анизоцитоза зависит от основной причины, и может включать в себя как медикаментозную терапию, так и коррекцию диеты.
Прогноз и возможные осложнения
Прогноз при анизоцитозе зависит от основной причины, вызвавшей это состояние. Анизоцитоз сам по себе не является заболеванием, а лишь симптомом, который может указывать на различные патологии. Важно провести тщательную диагностику, чтобы определить источник проблемы и начать соответствующее лечение.
Если анизоцитоз вызван дефицитом железа, то при адекватной терапии, включающей назначение железосодержащих препаратов и коррекцию диеты, прогноз обычно благоприятный. В большинстве случаев уровень гемоглобина и размеры эритроцитов нормализуются, что приводит к улучшению общего состояния пациента.
В случаях, когда анизоцитоз связан с хроническими заболеваниями, такими как анемия при хронической болезни или заболевания печени, прогноз может быть более сложным. Здесь важно контролировать основное заболевание, так как оно может влиять на уровень эритроцитов и их размеры. При успешном лечении основного заболевания возможно улучшение состояния крови и уменьшение анизоцитоза.
Однако анизоцитоз может также быть признаком более серьезных состояний, таких как злокачественные новообразования или тяжелые инфекционные процессы. В таких случаях прогноз будет зависеть от стадии заболевания и эффективности проводимого лечения. Раннее выявление и адекватная терапия могут значительно улучшить исход.
Что касается возможных осложнений, то анизоцитоз может привести к ухудшению кислородного обмена в организме, особенно если он сопровождается анемией. Это может проявляться в виде усталости, слабости, одышки и других симптомов. В тяжелых случаях может развиться сердечно-сосудистая недостаточность из-за недостатка кислорода, что требует немедленного вмешательства.
Кроме того, анизоцитоз может быть связан с нарушением гемостаза, что увеличивает риск тромбообразования или, наоборот, кровотечений. Поэтому важно не только выявить анизоцитоз, но и провести комплексное обследование для исключения сопутствующих нарушений.
Таким образом, прогноз и возможные осложнения при анизоцитозе зависят от его причины и общего состояния здоровья пациента. Регулярные обследования и контроль за состоянием крови помогут избежать серьезных последствий и своевременно скорректировать лечение.